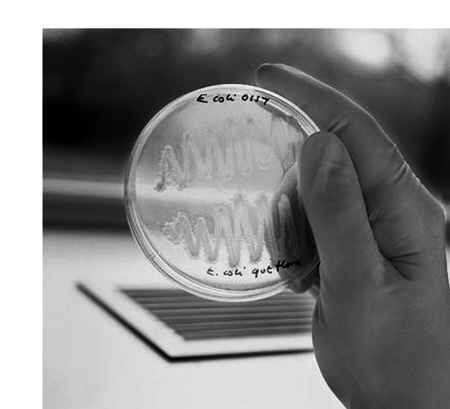

美提出生命进化新假说:两个原核生物造一个新生命
发布时间:2009-09-01
| 美提出生命进化新假说:两个原核生物造一个新生命 |

如果没有两个原核生物(没有细胞核的微小生命形式)在古代的融合,人类今天可能无法行走在地球表面。这是美国加州大学洛杉矶分校的分子生物学家詹姆斯·雷克在近期的《自然》杂志网络版上提出的关于原核生物与生命进化的最新重大见解。
内共生指的是一个细胞生活在另一个细胞内。如果两个细胞共存足够长的时间,就会交换基因。它们在融合的同时往往会保留自己的细胞膜,有时还会保留自己的基因组。
雷克首次发现了专属原核细胞的内共生现象。所有其他已知的内共生都涉及真核细胞——含有一个核的细胞。真核细胞可在包括人类在内的动物和植物等所有多细胞生命中找到。
雷克表示,这种关系产生了地球上完全不同的生命类型,以前人们总认为需要真核细胞才能做到这一点,但现在看来这是不对的。雷克在《自然》杂志发表的文章中指出,两组原核生物——放线菌和梭菌融合在一起产生了双膜原核生物。
雷克说,没有这一事件就不会产生更高级的生命。在当时,这两种早期原核生物正处于不断进化之中,且地球的大气层中还没有氧气。人类根本无法生存,只有无氧呼吸的生物体可以存活下来。
地球上氧气的出现是这些双膜原核生物的子群——蓝藻导致的。蓝藻利用太阳的能量经光合作用产生氧气。它们的产量非常之大,并将氧气泵入大气层中,人类没有它们就无法呼吸。此外,双膜原核生物的融合产生了存在于每个人体细胞中的线粒体。雷克说,双膜原核生物抓住了阳光这个巨大的能源,它们是如此成功,以至于它们要比其他原核生物具有更多的遗传多样性。
美国宇航局天体生物学研究所主任卡尔·皮尔彻表示,对于了解一群生物体如何学会利用阳光,从而影响到地球上曾经发生过的最大的环境变化来说,此项工作是一项重大的技术进步。
为了此项研究,雷克将时光回溯到了25亿年前,他对5组原核生物的基因组进行了分析。雷克拥有一个来自两个不同生物体(梭菌和放线菌)的基因流。因为进入流动的研究组别都拥有两个膜,所以研究人员假设这是一种可形成双膜的内共生现象,看起来就好像是一个单膜生物“席卷”了另一个单膜生物。基因组研究表明,双膜原核生物混合了两个不同生物体的基因。
雷克说,加州大学伯克利分校的阿兰·威尔逊是首个在世界各地从众多人群中收集DNA的人。他的研究表明,人类都和一位20万年前生活在非洲的女性有关,媒体称之为夏娃,而威尔逊则称之为“幸运母亲”,她是所有人的母亲。在此一研究领域,科学家们已获取了大量的数据,但无法了解其意义。内共生使人们开始能够理解此类信息,它告诉人们的是,许多基因已被交换过。
雷克表示,人们一直忽略了合作的重要性。如果两个原核生物走到一起,它们就可以改变世界。它们重构了地球的大气层。它给予我们的关于进化的信息就是:合作也是生命前进的一种方式。
作者:冯卫东 来源:科技日报 发布时间:2009-8-27 9:48:16



青公网安备 63010402000197号